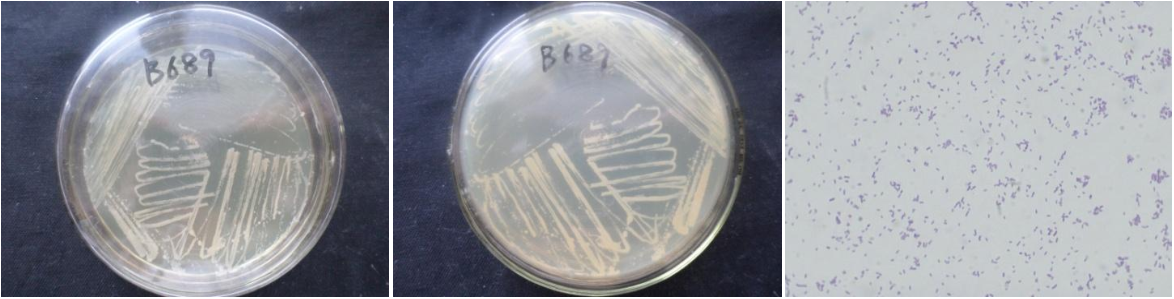

Loading...
| StrainNO | B689 |
| Classification | Halomonas |
| 16s rDNA sequence | ATGCAGTCGAGCGGCAGCACGGGGAGCTTGCTCCCTGGTGGCGAGCGGCGGACGGGTGAGTAATGCATAGGAATCTGCCCGGTA GTGGGGGATAACCTGGGGAAACCCAGGCTAATACCGCATACGTCCTACGGGAGAAAGCAGGGGCTCTTTGGACCTTGCGCTATC GGATGAGCCTATGTCGGATTAGCTGGTTGGTGAGGTAATGGCTCACCAAGGCGACGATCCGTAGCTGGTCTGAGAGGATGATCA GCCACATCGGGACTGAGACACGGCCCGAACTCCTACGGGAGGCAGCAGTGGGGAATATTGGACAATGGGCGCAAGCCTGATCCA GCCATGCCGCGTGTGTGAAGAAGGCCCTCGGGTTGTAAAGCACTTTCAGTGGGGAAGAAAGCCTGGCGGTTAATACCCGCCAGG AAGGACATCACCCACAGAAGAAGCACCGGCTAACTCCGTGCCAGCAGCCGCGGTAATACGGAGGGTGCGAGCGTTAATCGGAAT TACTGGGCGTAAAGCGCGCGTAGGCGGCTTGATAAGCCGGTTGTGAAAGCCCCGGGCTCAACCTGGGAATGGCATCCGGAACTG TCAGGCTAGAGTGCAGGAGAGGAAGGTAGAATTCCCGGTGTAGCGGTGAAATGCGTAGAGATCGGGAGGAATACCAGTGGCGAA GGCGGCCTTCTGGACTGACACTGACGCTGAGGTGCGAAAGCGTGGGTAGCAAACAGGATTAGATACCCTGGTAGTCCACGCCGT AAACGATGTCGACTAGCCGTTGGGTCCTTCGCGGACTTTGTGGCGCAGTTAACGCGATAAGTCGACCGCCTGGGGAGTACGGCC GCAAGGTTAAAACTCAAATGAATTGACGGGGGCCCGCACAAGCGGTGGAGCATGTGGTTTAATTCGATGCAACGCGAAGAACCT TACCTACCCTTGACATCCTGCGAACCCTTCGGAGACGAAGGGGTGCCTTCGGGAGCGCAGTGACAGGTGCTGCATGGCTGTCGT CAGCTCGTGTTGTGAAATGTTGGGTTAAGTCCCGTAACGAGCGCAACCCTTGTCCCTATTTGCCAGCGATTCGGTCGGGAACTC TAGGGAGACTGCCGGTGACAAACCGGAGGAAGGTGGGGACGACGTCAAGTCATCATGGCCCTTACGGGTAGGGCTACACACGTG CTACAATGGTTGGTACAAAGGGTTGCGAGCTCGCGAGAGCAAGCCAATCCCAGAAAGCCGATCTCAGTCCGGATCGGAGTCTGC AACTCGACTCCGTGAAGTCGGAATCGCTAGTAATCGTGAATCAGAATGTCACGGTGAATACGTTCCCGGGCCTTGTACACACCG CCCGTCACACCATGGGAGTGGACTGCACCAGAAGTGGTTAGCCTAACCTTCGGGAGGGCGATCACCACGGTGTGGTTCATGACT GGGGTGAAGT |
| Strain Morphology Photos | |
| Morphological Description | Colony round;milky white;edge neatly;steam bun shaped;slippy;sticky;Wax Sample;Bacteriophage Rod-shaped;no spore |